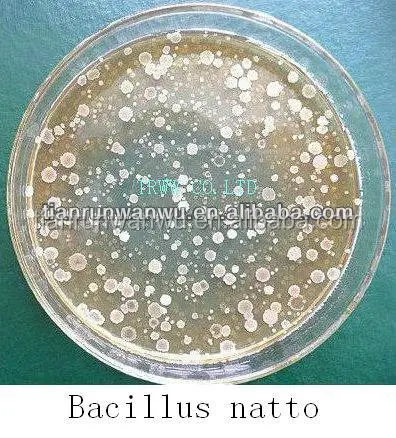
Bacillus natto (кормовой класс)

Bacillus natto (кормовой класс)
- Category: >>>
- Supplier: Cangzhou Tianrunwanwu Biotechnology Co. Ltd.
Share on (1635009240):
Product Overview
Description
Bacillus natto

[Main elements]: Bacillus natto, ferment metabolites.
[Character]: Light yellow powder.
[Biological feature]: One kind of bacillus, gram positive. The size of bacterium is generally (0.7-0.8)um×(2.0-3.0)um. The spore is oval or column, at center or near center, even if the sporocyst is expand, it’s not obviously, have flagella, can move. The living temperature of the highest is 45 to 55°C, the lowest is 5°C. The spore can bear acid, and can bear very heat. The cellular plasm growing in the dextrose agar culture medium dye evenly.
[Principle]: The natto bacteria of spore type are the beneficial bacteria having specialty of resisting acid and heat. The surviving percent is 100 in the gastric acid for 4 hours. Meanwhile, it has powerful function to inhibit the pathogenic bacteria, has the best tolerance to environment among various beneficial bacteria, and it is one kind of the bacteria to arrive at the small intestine directly. It can adjust the microbial balance of the intestinal bacteria after taken orally. It can generate acid, adjust the bacteria groups in intestinal tract, enhance the immune effect of animals’ cells, and generate several kinds of proteases (especially alkaline protease), saccharifying enzyme, lipase and amylase. It can degrade some complicated carbohydrate in plant feed.
[Main effect]: It can increase the conversion percent of feed.
[The quality index]:
The content of the living bacteria ( billion CFU per gram) | 10 |
The granularity of the product (mesh siever) | 60 to 100 |
The percent of moisture | Less than or equal to 10 |
[Using scope]: The feed ingredient of poultries, livestocks and aquatic animals, water adjusting, microbial feed.
[Storage]: Keep it at a shady cool and dry place.
[Quality guarantee period]: 24 months.
[Specification]: 25kg per bag.


We Recommend
New Arrivals
New products from manufacturers at wholesale prices